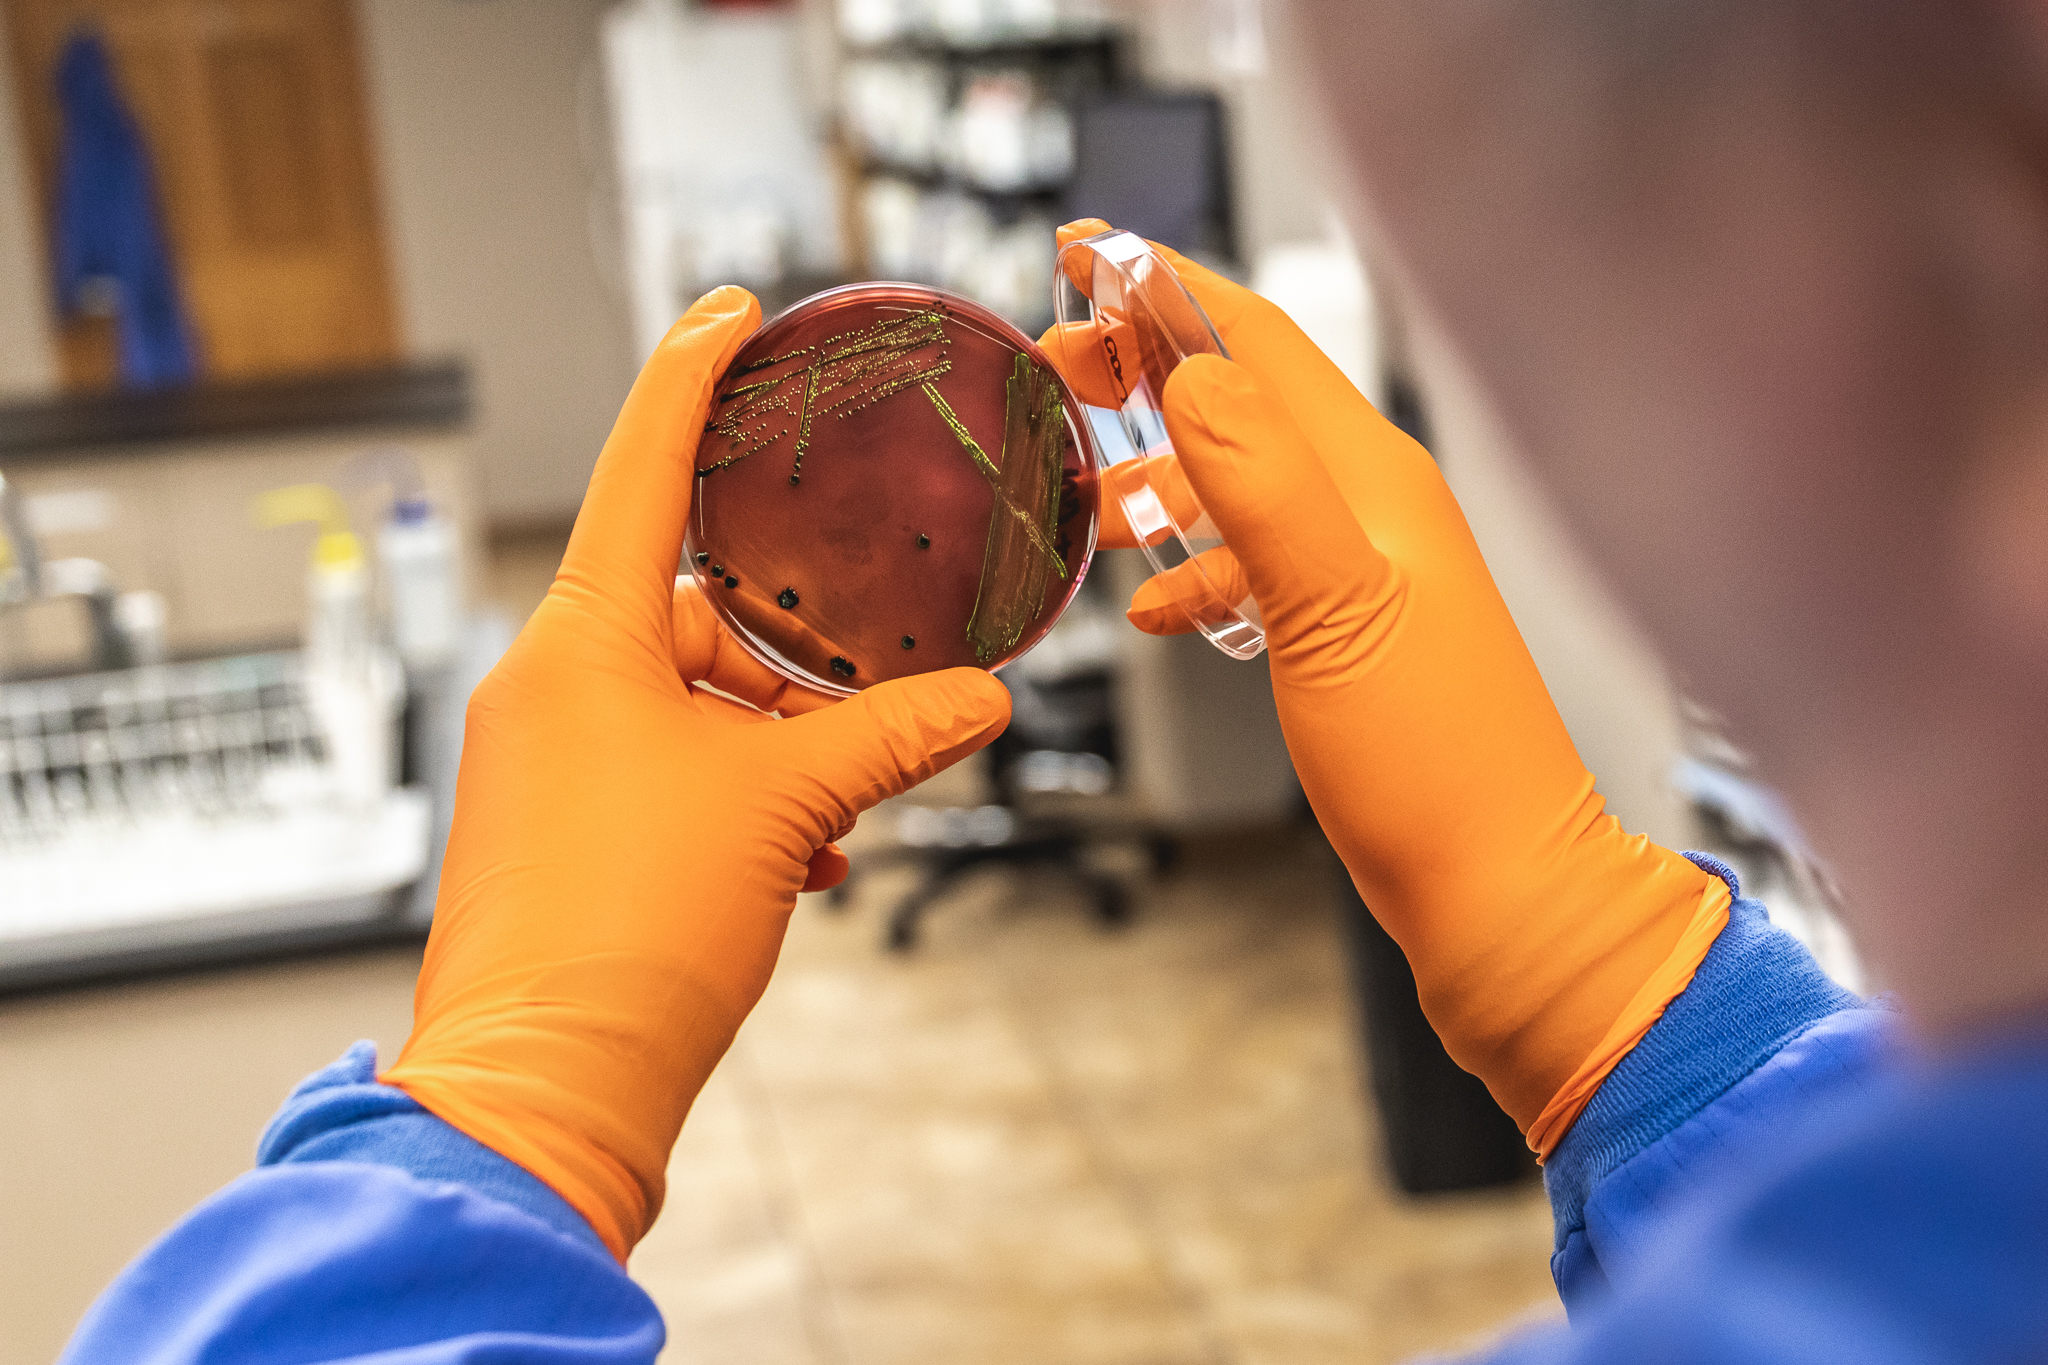

Challenge
A poultry processing plant in the U.S. was struggling with frequent positive Salmonella samples over an extended period. This plant was averaging more than one Salmonella positive per month on poultry parts. Several contributing factors were identified including both process and application inefficiencies.
The USDA Performance Standard for Salmonella on poultry parts is eight positive samples in a 52-week window. To be Category 1, the plant must be half the standard or 4 positive samples out of a 52-week window. Anything over 8 positive samples places the plant in Category 3 potentially subjecting them to a Food Safety Audit in addition to intensified sampling. Additionally, when a plant has a positive sample for Salmonella it remains on their record for one year.
Solution
The plant partnered with Safe Foods to develop a food safety action plan to return to Category 1 status for poultry parts. Safe Foods, a Fortrex company, is an industry leader in food safety with a strong history helping processors meet or exceed regulatory standards. The Safe Foods team worked together with plant leadership to create a joint action plan with accountability assigned to both groups.
The action plan included a variety of process and equipment modifications targeted at ensuring proper coverage and concentration targets. The Safe Foods team also conducted root cause investigations into operational anomalies and led training sessions with the plant to improve consistency and control. Additional enhancements included the installation of new sensors that tie into the Fortrex and Safe Foods MARC™ data analytics software.
Bi-weekly meetings between Safe Foods and the processing plant kept all stakeholders up to date on progress toward the end goal and assigned action items that each team was accountable to complete. These regular bilateral meetings are an essential part of the Fortrex and Safe Foods proven process for food safety performance. As the meetings progressed and various improvements were implemented, the plant team was empowered to establish and maintain process control. Using MARC’s™ data monitoring, alerting, and reporting capabilities, the team was able to track key metrics and make incremental changes to ensure the efficient operation of all food safety systems.
Result
Since implementing the joint action plan, the plant has decreased the monthly number of Salmonella positives on poultry parts by more than 55 percent. In addition, the plant is on track to achieve Category 1 status on poultry parts.
The Safe Foods team created a partnership for success with the processing client through honest feedback and mutual accountability. They continue to work together to manage the new food safety plan, monitoring the new processes and data closely to ensure consistency and continued progress.